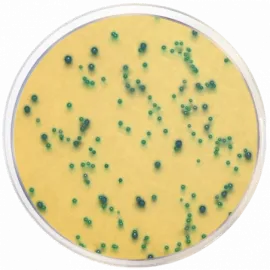
m-EI Chromogenic Agar Base, Modified
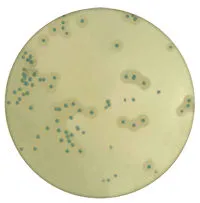
Listeria Chromogenic Lipase C Supplement

Microgen Bioproducts – Gold standards Diagnostics
|
Microgen® GN-ID A Panel 60 test MID64 |
|
Microgen GN-ID B panel kit MID65 |
|
Nitrate A (filled vial) MID61A |
|
Nitrate B filled vial MID61B |
|
VP I filled vial MID61C |
|
VP II filled vial MID61D |
|
TDA filled vial MID61E |
|
Indole Kovacs (filled vial) MID61F |
|
Microgen Oxidase Strips MID61G |
|
Mineral oil (filled vial) MID61H |
|
Microgen ID System Software CD MID60 |
- Categories : Microbiology, ,

.webp)